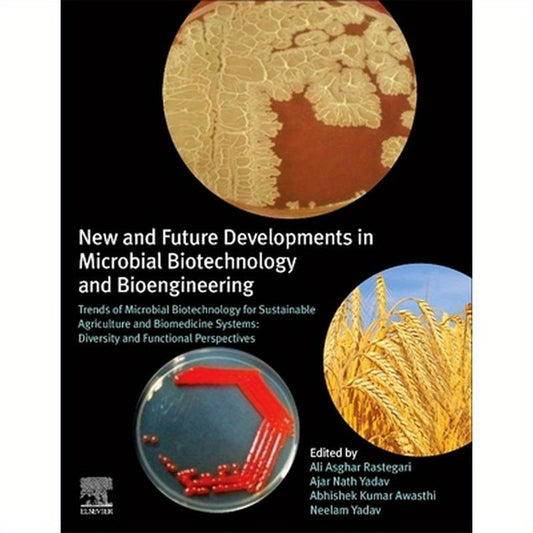
New and Future Developments in Microbial Biotechnology and Bioengineering: Trends of Microbial Biotechnology for Sustainable Agriculture and Biomedici

Collection: Business, Science and Technology
The triple driving force shaping the future. Scientific exploration of the unknown and discovery of natural laws; Technology transforms it into powerful tools, reshaping social boundaries; Business drives innovation to the market, solves practical problems, and creates inclusive value. This is the center where we observe this great interaction, from breakthroughs in the laboratory to changes in the market, tracking how ideas that truly change the world are born, grow, and impact everyone.
-
Quantum Materials, Devices, and Applications
Regular price $255.00Regular price -
Food Waste Recovery: Processing Technologies, Industrial Techniques, and Applications
Regular price $170.00Regular price -
Techno-Economic Challenges of Green Ammonia as an Energy Vector
Regular price $155.00Regular price -
Biocomposite and Synthetic Composites for Automotive Applications
Regular price $255.00Regular price -
Design, Fabrication, and Characterization of Multifunctional Nanomaterials
Regular price $205.00Regular price -
Applications of Multifunctional Nanomaterials
Regular price $225.00Regular price -
Biopolymer Science for Proteins and Peptides
Regular price $220.00Regular price -
Biodiesel Soot: Tribology, Properties, and Formation
Regular price $205.00Regular price -
Waste and Byproducts in Cement-Based Materials: Innovative Sustainable Materials for a Circular Economy
Regular price $355.00Regular price -
Sers for Point-Of-Care and Clinical Applications
Regular price $135.00Regular price -
Making Hands: A History of Prosthetic Arms
Regular price $130.00Regular price -
Human-Machine Shared Contexts
Regular price $155.00Regular price -
Natural Polymers-Based Green Adsorbents for Water Treatment
Regular price $235.00Regular price -
Renewable-Energy-Driven Future: Technologies, Modelling, Applications, Sustainability and Policies
Regular price $170.00Regular price -
Paper-Based Analytical Devices for Chemical Analysis and Diagnostics
Regular price $220.00Regular price -
Photocatalytic Systems by Design: Materials, Mechanisms and Applications
Regular price $225.00Regular price -
The Thermodynamics of Phase and Reaction Equilibria
Regular price $185.00Regular price -
New and Future Developments in Microbial Biotechnology and Bioengineering: Trends of Microbial Biotechnology for Sustainable Agriculture and Biomedici
Regular price $235.00Regular price -
New and Future Developments in Microbial Biotechnology and Bioengineering: Trends of Microbial Biotechnology for Sustainable Agriculture and Biomedici
Regular price $235.00Regular price -
Bioremediation for Environmental Sustainability: Toxicity, Mechanisms of Contaminants Degradation, Detoxification and Challenges
Regular price $235.00Regular price -
Food Security and Nutrition
Regular price $180.00Regular price -
New Perspectives on Early Social-Cognitive Development: Volume 254
Regular price $293.00Regular price -
Neurotoxicity of Pesticides: Volume 4
Regular price $220.00Regular price -
Basics of Computational Geophysics
Regular price $185.00Regular price